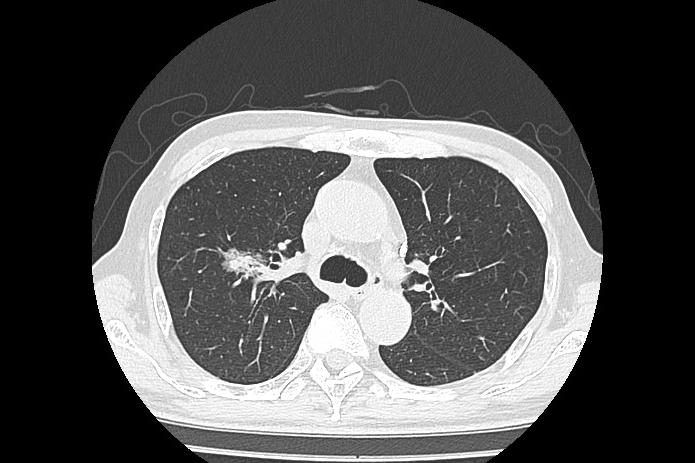
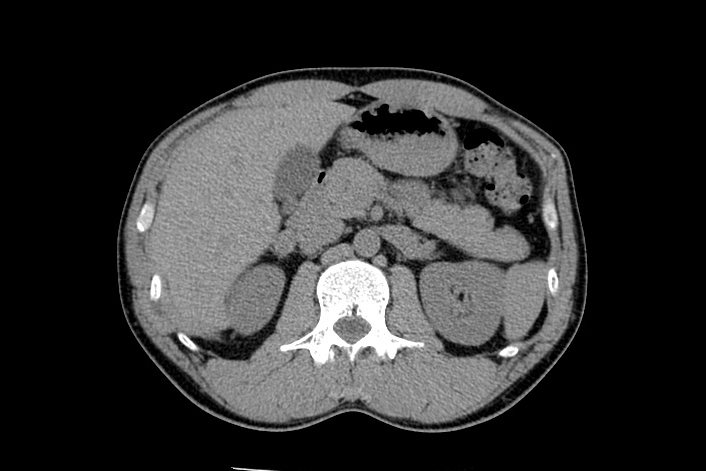

MRI検査
頭部MRI・MRA
MRIはGE社製1.5T SIGNA Explorerを使用しています。MRI検査は放射線を使用せずに磁気共鳴によって画像化します。
当施設では、頭部領域、脊椎、上腹部、骨盤、四肢など多種多様な部位においての検査を行っております。
この装置は消音・静音化技術が搭載されており検査環境が改善されています。
また検査時間が長い為、動きの影響を受けやすいですが、体動補正技術を取り入れているため、じっとしてる事が困難な患者様の頭部検査が可能となりました。
物忘れ検査VSRAD
頭部MRI検査のオプション検査としてVSRAD(早期アルツハイマー型認知症診断支援システム)を行っています。脳の萎縮を、MRI画像を用いた画像統計解析処理によって視覚的に読み取ることができます。※ただし、50歳以上の方が対象となります。
その他
CT検査
胸部CT
CTはGE社製16列MDCT Brivo CT385を使用しています。CT検査ではX線を人体に照射し、体内を通過したX線量をコンピュータでデータ処理することで画像化しています。一般のX線写真では分からないような微細な体内の情報を得ることができます。また、MRI検査とは異なり短時間で検査することができます。また、最新の被ばく低減技術を搭載することで、低被ばくの検査を実現し、特に被ばく感受性の高い部位である、水晶体・甲状腺・乳腺においても、自動コントロール機能を有することで、最適な検査を実現します。
胸部CTでは、肺がんが心配な方、タバコを吸っている(いた)方、周りの副流煙が気になる方など胸部X線写真で骨に重なって判断しにくい病変が、CTでははっきりと写し出すことができます。
腹部CT
腹部CTでは、上腹部臓器(肝臓、膵臓、胆のう、腎臓など)の診断に優れ、骨盤内臓器(女性:子宮卵巣、男性:前立腺)を含めた腹部全体を写し出します。超音波検査では見えにくい、深部臓器(特に膵臓)の描出が可能になります。
内臓脂肪CT
内臓脂肪CTでは、メタボリック症候群を疑うポッコリお腹の内臓脂肪量を計測します。結果は、内臓脂肪、皮下脂肪画像を表示したレポートをお渡しています。
その他
一般撮影
X線撮影装置、乳房撮影装置、デジタルX線TV装置があり、様々な検査に対応しています。撮影にはFPD(フラットパネルディテクタ)を用いており、低被ばく・高画質な画像が提供できます。